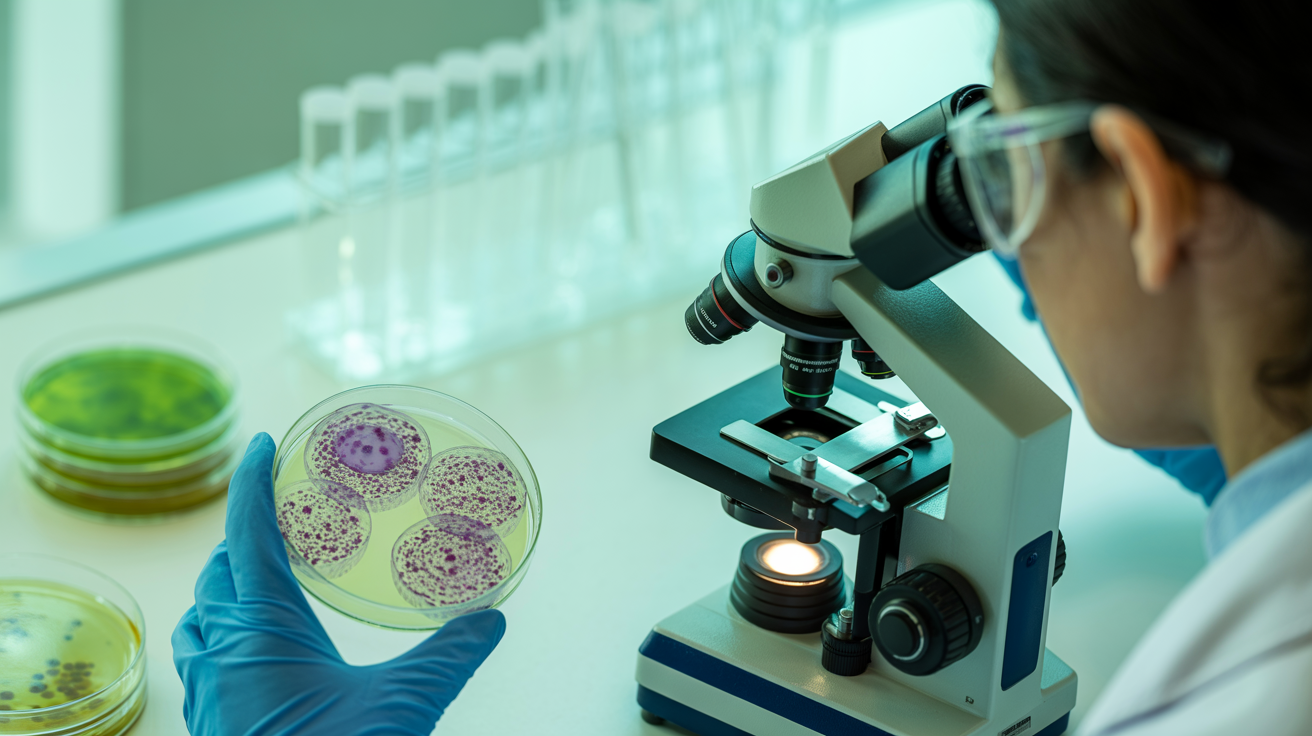
Klinische Studie: FMD aktiviert nachweislich Autophagie beim Menschen

Durchbruch in der Fastenforschung: Erste Humanstudie beweist Autophagie-Aktivierung durch Scheinfasten
Neue Studie zeigt erstmals direkt beim Menschen: Scheinfasten aktiviert die zelluläre Selbstreinigung und verbessert gleichzeitig wichtige Gesundheitsmarker.
Weiterlesen